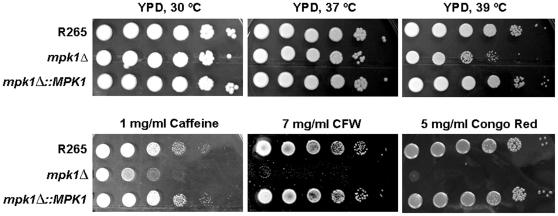

荚膜组织胞浆菌毒力复合群:高毒力和低毒力温哥华岛暴发株的芯片分析揭示的候选基因。
Cryptococcus gattii virulence composite: candidate genes revealed by microarray analysis of high and less virulent Vancouver island outbreak strains.
机构信息
Molecular Mycology Research Laboratory, Centre for Infectious Diseases and Microbiology, Sydney Medical School-Westmead, Westmead Millennium Institute, Sydney Emerging Infections and Biosecurity Institute, The University of Sydney, Westmead Hospital, Westmead, New South Wales, Australia.
出版信息
PLoS One. 2011 Jan 13;6(1):e16076. doi: 10.1371/journal.pone.0016076.
Human and animal cryptococcosis due to an unusual molecular type of Cryptococcus gattii (VGII) emerged recently on Vancouver Island, Canada. Unlike C. neoformans, C. gattii causes disease mainly in immunocompetent hosts, despite producing a similar suite of virulence determinants. To investigate a potential relationship between the regulation of expression of a virulence gene composite and virulence, we took advantage of two subtypes of VGII (a and b), one highly virulent (R265) and one less virulent (R272), that were identified from the Vancouver outbreak. By expression microarray analysis, 202 genes showed at least a 2-fold difference in expression with 108 being up- and 94 being down-regulated in strain R265 compared with strain R272. Specifically, expression levels of genes encoding putative virulence factors (e.g. LAC1, LAC2, CAS3 and MPK1) and genes encoding proteins involved in cell wall assembly, carbohydrate and lipid metabolism were increased in strain R265, whereas genes involved in the regulation of mitosis and ergosterol biosynthesis were suppressed. In vitro phenotypic studies and transcription analysis confirmed the microarray results. Gene disruption of LAC1 and MPK1 revealed defects in melanin synthesis and cell wall integrity, respectively, where CAS3 was not essential for capsule production. Moreover, MPK1 also controls melanin and capsule production and causes a severe attenuation of the virulence in a murine inhalational model. Overall, this study provides the basis for further genetic studies to characterize the differences in the virulence composite of strains with minor evolutionary divergences in gene expression in the primary pathogen C. gattii, that have led to a major invasive fungal infection outbreak.
人及动物隐球菌病是由一种不常见的新型隐球菌分子类型(VGII)引起的,该新型隐球菌最近在加拿大温哥华岛出现。与新型隐球菌不同,新型隐球菌主要引起免疫功能正常宿主的疾病,尽管它产生了类似的一组毒力决定因素。为了研究表达调控与毒力之间的潜在关系,我们利用了从温哥华疫情中鉴定出的两个 VGII 亚型(a 和 b),一个高度毒力(R265)和一个低毒力(R272)。通过表达微阵列分析,202 个基因的表达差异至少为 2 倍,其中 108 个基因上调,94 个基因下调,与 R272 相比,R265 中表达。具体来说,编码假定毒力因子(如 LAC1、LAC2、CAS3 和 MPK1)的基因和参与细胞壁组装、碳水化合物和脂质代谢的基因的表达水平在 R265 中增加,而参与有丝分裂和麦角固醇生物合成调节的基因则受到抑制。体外表型研究和转录分析证实了微阵列结果。LAC1 和 MPK1 基因的敲除分别导致黑色素合成和细胞壁完整性缺陷,而 CAS3 对荚膜产生不是必需的。此外,MPK1 还控制黑色素和荚膜的产生,并导致在小鼠吸入模型中的毒力严重减弱。总的来说,这项研究为进一步的遗传研究提供了基础,以表征在主要病原体新型隐球菌中,基因表达的微小进化差异导致的毒力复合差异,这导致了一次重大的侵袭性真菌感染爆发。